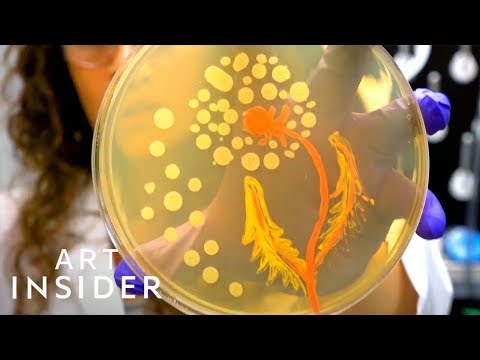
大腸桿菌可以拿來作畫！？而且還真的美美的！ (Germ Art Is Helping Change The Way We Think About Bacteria)

10,000 個「 海口外围人妖TS客服微信(微信hz93703)海口高端外围全球资源线上选人同城半小时内见面满意付款,外围圈官网(waiweiquan.com)选人备注来意.keyc 」的搜尋結果
依關聯性
 43:36
43:36字幕已審核 06:15
06:15
 06:15
06:15 05:59
05:59 15:52
15:52字幕已審核 03:35
03:35
03:35
03:35字幕已審核 03:07
03:07
 03:07
03:07 04:51
04:51 06:40
06:40 13:35
13:35 09:00
09:00 12:03
12:03字幕已審核 03:43
03:43
 03:43
03:43 22:30
22:30 04:47
04:47 07:41
07:41 04:54
04:54 03:51
03:51 11:40
11:40 06:34
06:34 05:35
05:35 06:22
06:22 27:51
27:51 03:29
03:29














![想成為過敏免疫專科醫師?[第44集] (So You Want to Be an ALLERGIST/IMMUNOLOGIST [Ep. 44])](https://img.youtube.com/vi/5a1otbNEBXI/hqdefault.jpg)






